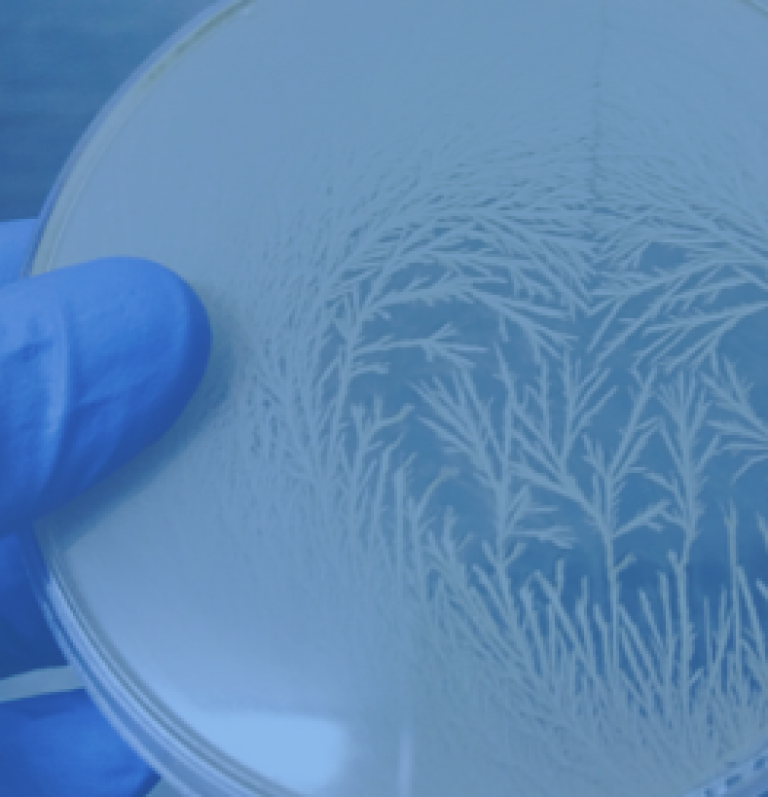

Unidades






Destacados
Dictuc a través de sus unidades, entrega servicios en diversos temas de interés país, para resolver problemas específicos de sus clientes y/o desarrollar proyectos de gran envergadura, relevantes y diversos para el país.